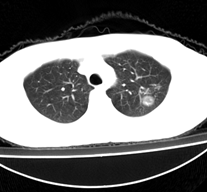
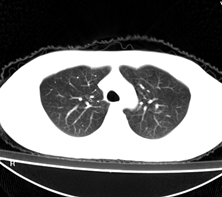

医影在线
标题: CT3009:胸部,健康体检发现,诉无任何不适 [打印本页]
作者: caolun 时间: 2006-3-16 23:56
标题: CT3009:胸部,健康体检发现,诉无任何不适
病人为一考上研究生的学生,健康体检发现。请踊跃发表意见。










[本贴已被 jiajie 于 2006-3-16 17:17:23 修改过]
作者: nhrmyy 时间: 2006-3-17 00:11
左肺上叶见后段近侧胸壁见两个薄壁空洞影,洞内无液平,考虑肺囊肿,因为肺囊肿位于肺的外周,囊肿与支气管相通,囊壁薄,囊内无液性成分。以上使我的观点,原与各位交流
作者: qiuse 时间: 2006-3-17 00:22
有点道理
支持
作者: slc0002slc 时间: 2006-3-17 00:50
薄壁空洞影,内无液平,
首先考虑结核,囊肿的壁更薄,合并感染时才会象这样,但周围有感染灶。
作者: chen123 时间: 2006-3-17 01:49
同意楼上
作者: soniclou 时间: 2006-3-17 02:59
囊性空洞,考虑结核球
作者: ssl1_1 时间: 2006-3-17 03:02
结核
作者: duanchao 时间: 2006-3-17 03:05
标题: 回复:ct3009:胸部,健康体检发现,诉无任何不适
以下是引用slc0002slc在2006-3-16 16:50:00的发言:[br]薄壁空洞影,内无液平,[br]首先考虑结核,囊肿的壁更薄,合并感染时才会象这样,但周围有感染灶。
[emb6]
作者: jiajie 时间: 2006-3-17 03:14
左肺上叶尖后段胸膜下可见两个类圆形薄壁空洞,内外壁较光滑,腔内为气体密度,支持结核性薄壁空洞。
作者: 绿水青山 时间: 2006-3-17 03:50
空洞壁高密度、首先陈旧性结核空洞
作者: wxh369 时间: 2006-3-17 03:53
支持肺囊肿
作者: 乡医 时间: 2006-3-17 03:59
标题: 回复:ct3009:胸部,健康体检发现,诉无任何不适
以下是引用jiajie在2006-3-16 19:14:00的发言:[br]左肺上叶尖后段胸膜下可见两个类圆形薄壁空洞,内外壁较光滑,腔内为气体密度,支持结核性薄壁空洞。
作者: 同 时间: 2006-3-17 04:10
支持肺结核
作者: drzhang8888 时间: 2006-3-17 04:12
支持12楼。
作者: kbzyycm 时间: 2006-3-17 04:19
陈旧性结核空洞
作者: 海洋人 时间: 2006-3-17 04:20
我想应是肺囊肿,因为边界清晰,其内无液平面,周边没有卫星灶,还有临床也不支持肺结核
作者: fengchanglin 时间: 2006-3-17 04:28
首先考虑结核
作者: hzw19711230 时间: 2006-3-17 04:30
左上肺结核空洞。
作者: 流星1234 时间: 2006-3-17 04:35
支持结核性空洞
作者: maqingya 时间: 2006-3-17 04:35
韦格肉牙肿
作者: liuyongbinking 时间: 2006-3-17 04:51
我支持陈旧性结核空洞。临床上已愈合,但是仍可有空洞存在。
作者: 迎客松 时间: 2006-3-17 04:53
标题: [乱弹]
临床无症状,左上肺两枚厚壁空洞,内无气液平面,周围未见卫星灶,囊肿可能大,建议追问病史。请各位老师指正
[本贴已被 迎客松 于 2006-3-16 20:57:01 修改过]
作者: wxy7406 时间: 2006-3-17 04:59
左飞上叶尖后段两个含气的囊性肿块,边界清晰,其周围未见卫星病灶,考虑肺囊肿.不支持肺结核是因为未见卫星灶,临床未见体征.
作者: caihe 时间: 2006-3-17 05:10
认为肺囊肿可能极大,不支持肺结核空洞。
作者: 拾荒者 时间: 2006-3-17 05:33
左肺上叶后段见两个孤立圆形厚壁空洞,无液平及壁结节。周围清晰,无卫星灶。结合病史,如此大的病灶病人毫无感觉,另外周围如此清晰,应能排除结核空洞;肺囊肿壁应更薄,如合并感染可增厚,但周围应模糊。本人考虑:肺韦格肉芽肿。
作者: 常文浩 时间: 2006-3-17 05:51
是不是陈旧性的结核空洞啊?会不会是肺脓肿呢?
作者: xuemingxiao 时间: 2006-3-17 05:59
薄壁空洞,典型“印戒”征,应该考虑结核可能性大。请各位老师批评指正!!!
作者: jiangjing 时间: 2006-3-17 06:44
左肺上叶后段见两个孤立圆形厚壁空洞,无液平及壁结节。周围清晰,无卫星灶。结合病史,如此的病灶病人毫无感觉.考虑1肺部感染[注意新隐球菌感染----中华放射学杂志---2006----第一期-----104页]。2肺囊肿。请指教!!!
作者: skystar 时间: 2006-3-17 07:07
左上叶尖后段可见两个中等壁厚空洞,腔内无液平,内外壁光整,局部轻度胸膜增厚,首虑结核。
不知左下有无播散灶?
另 肺魏格氏肉芽肿空洞内壁不规则,“印戒”征用来描述“支扩”ct征像会更贴切。
作者: wawaquan 时间: 2006-3-17 07:12
支持韦格氏肉牙肿。
作者: zryfb7719 时间: 2006-3-17 07:52
空洞:肺内病变坏死,坏死组织经支气管引流排除后形成空洞。见于结核、肺脓肿、肺癌、霉菌病及韦氏肉芽肿等。
薄壁空洞:洞壁在2~3mm之下,多见于肺结核。表现为圆形、椭圆形、或不规则形状的环形,洞壁内外光滑清楚,一般洞内无液气平面,周围很少实变影。
肺气囊空腔:腔壁为肺泡壁<1mm,周围无病变,感染时可有腔内液平面,周围可有斑片影。
作者: huangaiying1 时间: 2006-3-17 17:32
考虑肺囊肿可能性大。不支持结核是因为周围肺野内未见明显卫星灶及纤维索条,不支持韦格氏肉芽肿是因为内壁及外壁均很光整,壁厚薄一致,而韦格氏肉芽肿洞壁厚薄多不均匀,内壁多不规则,其内可有形态不规则的内容物。
作者: xhsmx 时间: 2006-3-17 18:00
肺囊肿多见于中下肺,上肺少见,且壁薄。该例有卫星灶更象结核空洞。
作者: 王永利 时间: 2006-3-17 18:11
我觉得是肺囊肿,另外请教一下壁的厚薄用肺窗观察还是用纵隔窗?
作者: 山野樵夫 时间: 2006-3-17 18:14
支持陈旧性结核空洞
作者: wuzhenan 时间: 2006-3-17 19:03
左肺尖后段的两个薄壁(纵隔窗)含气囊样病变,壁厚薄较均匀、光整、内无液气平形成、其邻近肺野见
少许渗出、未见卫星灶,其余肺野未见明显支气管播散灶(楼主虽然未上传全其他层面图片,但认为因正常而未上传)。
综合上述:考虑为肺囊肿合并感染,不支持结核空洞(虽然病变位于结核好发区,但认为这么明显的结核空洞应该有明显的肺内支气管播散灶)。
作者: zhuxinli 时间: 2006-3-17 20:16
我想应是肺囊肿,因为边界清晰,其内无液平面,周边没有卫星灶
作者: 沧海一笑518 时间: 2006-3-18 07:59
肺囊肿并感染
作者: shibing 时间: 2015-6-3 11:15
空洞壁高密度、首先陈旧性结核空洞
| 欢迎光临 医影在线 (http://bbs.radida.com/bbs/) |
Powered by Discuz! X3.2 |